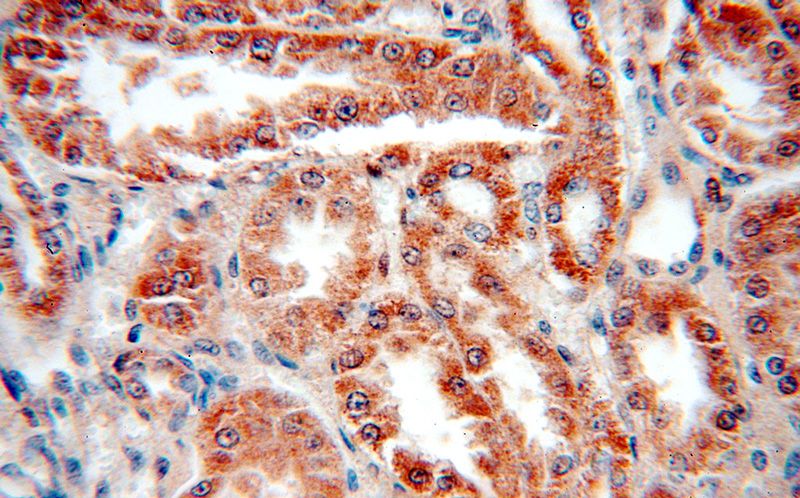
Immunohistochemical of paraffin-embedded human kidney using Catalog No:113627(PDK4 antibody) at dilution of 1:50 (under 40x lens)

-
Product Name
PDK4 antibody
- Documents
-
Description
PDK4 Rabbit Polyclonal antibody. Positive WB detected in mouse heart tissue, human heart tissue, human placenta tissue, mouse skeletal muscle tissue, rat heart tissue. Positive IHC detected in human kidney tissue, human skeletal muscle tissue. Observed molecular weight by Western-blot: 46 kDa
-
Tested applications
ELISA, WB, IHC
-
Species reactivity
Human,Mouse,Rat; other species not tested.
-
Alternative names
FLJ40832 antibody; PDK4 antibody
-
Isotype
Rabbit IgG
-
Preparation
This antibody was obtained by immunization of PDK4 recombinant protein (Accession Number: NM_002612). Purification method: Antigen affinity purified.
-
Clonality
Polyclonal
-
Formulation
PBS with 0.1% sodium azide and 50% glycerol pH 7.3.
-
Storage instructions
Store at -20℃. DO NOT ALIQUOT
-
Applications
Recommended Dilution:
WB: 1:200-1:1000
IHC: 1:20-1:200
-
Validations

mouse heart tissue were subjected to SDS PAGE followed by western blot with Catalog No:113627(PDK4 antibody) at dilution of 1:1000

Immunohistochemical of paraffin-embedded human kidney using Catalog No:113627(PDK4 antibody) at dilution of 1:50 (under 10x lens)
Immunohistochemical of paraffin-embedded human kidney using Catalog No:113627(PDK4 antibody) at dilution of 1:50 (under 40x lens)
-
Background
Pyruvate dehydrogenase kinase isoform4 (PDK4) is also named as PDHK4 and belongs to the PDK/BCKDK protein kinase family.It is upregulated by starvation in many tissues of the body during starvation. This causes inactivation of the pyruvatedehydrogenase complex which blocks pyruvate oxidation and conserves lactate and alanine for gluconeogenesis. Enhanced PDK4 expression may be caused by the increase in free fatty acids that occurs during starvation. Free fatty acids can activate peroxisome proliferator-activated receptor α (PPARα), and activation of PPARα can promote PDK4 expression(PMID:11554740).
-
References
- Strand DW, Jiang M, Murphy TA. PPARγ isoforms differentially regulate metabolic networks to mediate mouse prostatic epithelial differentiation. Cell death & disease. 3:e361. 2012.
- Kemmerer M, Finkernagel F, Cavalcante MF. AMP-Activated Protein Kinase Interacts with the Peroxisome Proliferator-Activated Receptor Delta to Induce Genes Affecting Fatty Acid Oxidation in Human Macrophages. PloS one. 10(6):e0130893. 2015.
Related Products / Services
Please note: All products are "FOR RESEARCH USE ONLY AND ARE NOT INTENDED FOR DIAGNOSTIC OR THERAPEUTIC USE"
